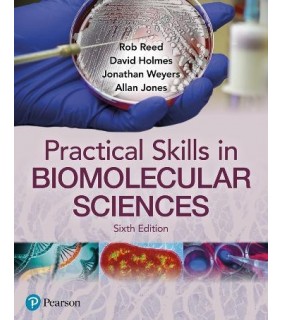

-
Wilson and Walker's Principles and Techniques of Biochemistry and Molecular Biology
$75.95
$64.56
quick look
- ISBN: 9781316614761
-
Cambridge University Press Wilson and Walker's Principles and Techniques of Biochemistr
$232.95quick look
- ISBN: 9781107162273
-
Pearson Education Practical Skills in Biomolecular Science, 6th edition
$103.95quick look
- ISBN: 9781292397085